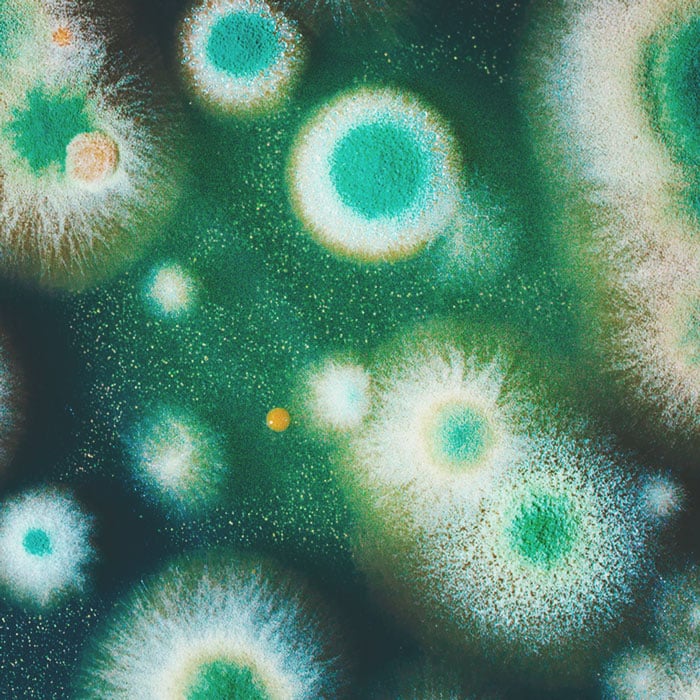

.

Menthe poivrée et cannabis : les bienfaits du compagnonnage des plantes
Il y a plusieurs raisons d’envisager de mettre de la menthe dans votre jardin de cannabis. Oui, c’est bon dans les boissons et les plats, mais c’est bien plus utile en culture. Les molécules phytochimiques de la menthe aident à éloigner les espèces nuisibles, à attirer les prédateurs bénéfiques et à renforcer les défenses des plantes environnantes.
Sommaire:
- Ce qu’il faut savoir sur la famille de la menthe
- Quels sont les bienfaits de la menthe dans votre jardin de cannabis ?
- Compagnonnage végétal du cannabis : comment cultiver de la menthe
- Quels sont les risques à cultiver de la menthe dans votre jardin de cannabis ?
- Le cannabis et la menthe : une vie en harmonie
Bien sûr, le cannabis poussera seul, mais il préfère vraiment la présence d’autres plantes. Les espèces compagnes bénéfiques, dont la menthe, aident à éloigner les nuisibles et à attirer les insectes[4] bénéfiques. De plus, les molécules de la menthe sont considérées comme améliorant potentiellement les profils terpéniques de l’herbe. Découvrez plus bas comment utiliser la menthe au bénéfice de votre culture de cannabis.
Ce qu’il faut savoir sur la famille de la menthe
La menthe. Cette plante simple contribue aux notes rafraîchissantes des mojitos, des tisanes et des salades. Même si vous ne la voyez pas, vous reconnaîtrez certainement son goût particulier en croquant ou buvant un plat ou une boisson contenant de la menthe. Avec d’autres herbes aromatiques indispensables, comme le thym, l’origan, la sauge et le romarin, la menthe fait partie de la famille des Lamiacées. Ensemble, ces plantes sont derrière les goûts agréables d’innombrables créations délicieuses.
Ce que beaucoup d’entre nous appellent la menthe est en fait un ensemble de plantes faisant partie du genre Mentha. Parmi les espèces bien connues, on peut citer la menthe verte (Mentha spicata), la menthe odorante (Mentha suaveolens) et la menthe poivrée (Mentha x piperita).
On retrouve des membres de la famille de la menthe dans le monde entier, de l’Europe et du sud de l’Afrique jusqu’en Asie et en Australie. Que ce soit dans la nature ou bien dans un jardin, elle s’épanouit près des plans d’eau sous une ombre partielle. Sa nature vivace signifie qu’elle revient année après année. Les jardiniers ont rarement besoin de semer des graines pour que cette plante continue à pousser.
Les espèces de menthe sont une riche source de molécules phytochimiques, avec beaucoup de phénols, de flavonoïdes, de glycosides et de tannins. Elles contiennent également des terpènes, les hydrocarbures à l’origine des odeurs du cannabis, comme du menthol, du menthone et du cinéole[5].
Au-delà de ses applications culinaires, la menthe est choisie par de nombreux jardiniers pour ses fonctions en tant que plante compagne. Des témoignages affirment que les espèces de menthe sont efficaces pour repousser les nuisibles[6] et améliorer la croissance des plantes environnantes.


Est-ce que la menthe et la menthe poivrée sont la même chose ?
On se répète, mais le terme « menthe » ne fait pas référence à une espèce de plante unique. C’est plutôt un synonyme de « Mentha », le genre entier des menthes. En revanche, « menthe poivrée » fait référence à une espèce de plante spécifique au sein de ce genre. La menthe poivrée est un hybride, créé par des sélectionneurs en croisant la menthe verte et la menthe aquatique. Originaire d’Europe, cette espèce pousse désormais dans le monde entier. Des systèmes de médecine traditionnelle utilisent cette espèce contre des problèmes[7] digestifs et respiratoires et des études actuelles cherchent à confirmer ces bienfaits.
Quels sont les bienfaits de la menthe dans votre jardin de cannabis ?
Bien sûr, la menthe donnera une bonne odeur à votre jardin. Mais l’étendue de l’impact va bien plus loin qu’une simple touche aromatique. Les espèces de menthe sont efficaces pour éloigner les insectes[8], cacher les plants d’herbe et (potentiellement) améliorer les parfums des fleurs de cannabis. Après avoir récolté vos têtes, vous pouvez aussi attraper des poignées de feuilles de menthe et les emporter en cuisine pour tout un tas d’applications.
Contrôle des nuisibles
La prochaine fois que vous êtes à proximité d’un plant de menthe, frottez une feuille entre vos doigts et prenez un moment pour sentir le bon parfum. Cette odeur vient de composés produits pour plusieurs raisons, dont la défense des plantes. En tant que métabolites secondaires, ils ne sont pas directement impliqués dans la croissance et la reproduction, mais ils jouent un rôle important pour la survie des plantes.
Parmi de nombreux composés phytochimiques différents, les plants de menthe contiennent des multitudes de terpènes. Ces hydrocarbures volatiles sont à la base des agents dans une guerre chimique. Comme leur odeur est si puissante, ils agissent en décourageant les insectes herbivores[1] de se nourrir. Ceux qui ont assez faim pour plonger leurs crocs dans les tissus végétaux en subissent les conséquences, car certains terpènes infligent des effets toxiques qui perturbent l’alimentation et la reproduction. Ces molécules sont également capables de changer le comportement des insectes en les rendant moins capables de détecter certaines plantes.
Les plants de menthe pourraient également alerter vos plants de cannabis quand les insectes nuisibles rôdent. Quand des insectes attaquent les tissus végétaux, ils déclenchent la libération de terpènes volatiles[9] dans l’air. Ces molécules agissent comme des signaux pour alerter les plantes environnantes, ce qui les pousse à renforcer la production de molécules chimiques toxiques créées pour repousser les insectes.


Camouflage aromatique
Le plant de cannabis produit plus de 150 composés terpéniques différents qui contribuent aux goûts et odeurs particuliers et diversifiés de chaque variété. Le puissant parfum « de Skunk » qui peut facilement faire repérer une culture est cependant dû à des composés sulfurés volatiles[2].
Heureusement, la menthe émet aussi une forte odeur reconnaissable qui peut masquer votre herbe. On peut la sentir quand elle pousse à plusieurs mètres à la ronde et des plants plus grands peuvent envoyer leurs composés volatiles bien plus loin. Plantez-en assez autour de votre jardin de cannabis et vous masquerez partiellement l’odeur évidente de l’herbe pendant la phase de floraison du cycle de culture.
Utilisations holistiques et culinaires
Il y a plusieurs raisons à faire pousser de la menthe dans votre jardin au-delà de la protection et du camouflage pour vos plants d’herbe. Cette plante robuste et utile est un ingrédient important dans plusieurs recettes et présente aussi un potentiel holistique. Coupez quelques branches de votre plant de menthe à chaque fois que vous avez envie de préparer ce qui suit :
- Eau à la menthe 🚰
- Pesto 🍲
- Soupes 🍜
- Salades 🥗
- Sirop 🍯
- Thé 🍵
- Mojito 🍹
- Glaces 🍦
Certaines espèces de menthe ont une longue histoire d’utilisation thérapeutique au sein de certaines populations : les peuplades indigènes des Andes apprécient le genre Minthostachys de menthe sud-américaine pour ses propriétés médicinales[3] supposées. Des études en cours explorent le potentiel de la menthe et de ses multitudes de molécules dans les contextes suivants :
• Digestion

• Problèmes respiratoires et mal de gorge

• Potentiel antimicrobien
• Douleurs et inconforts

• Stress


Améliorer le goût du cannabis
Ça peut sembler tiré par les cheveux, mais restez avec nous ! Comme on l’a évoqué plus haut, il se trouve que certaines plantes libèrent des terpènes dans l’air[10] lorsqu’elles sont attaquées. À la place d’un cri de douleur, cette projection aromatique sert de signe d’avertissement aux voisins végétaux environnants. Une fois qu’elles l’ont détecté, les autres plantes commencent à augmenter la production de métabolites secondaires qui aident à combattre les formes de stress biotiques (vivantes) et abiotiques (non-vivantes).
En se basant sur ce point, certains cultivateurs affirment que le fait de planter de la menthe et d’autres herbes aromatiques à proximité du cannabis crée des profils terpéniques plus favorables. Non, les terpènes de la menthe n’atterrissent pas physiquement sur les fleurs de cannabis en modifiant leur parfum. En revanche, elles réagissent simplement aux terpènes d’autres plantes et modulent la production de ces molécules. Alors que les études sont rares sur l’interaction chimique spécifique entre la menthe et le cannabis, la science a confirmé l’action de signalisation des terpènes.
Compagnonnage végétal du cannabis : comment cultiver de la menthe
Après avoir découvert le rôle que la menthe peut jouer dans un jardin de cannabis, vous avez probablement hâte de semer des graines en terre. Voici un guide simple pour obtenir une saine population de menthe.
Si vous lisez cet article au début du printemps, vous avez largement le temps de semer des graines de menthe. Placez les graines dans un plateau de semis rempli d’un terreau léger environ 8–10 semaines avant les dernières gelées dans votre région. Couvrez-les de 0,5 cm et aspergez-les légèrement d’eau. Utilisez un tapis chauffant, si nécessaire, pour entretenir une température constante de 21 °C et les graines germeront en 1–2 semaines.
Dès la germination, placez les semis sous une lampe de culture, ou sur un rebord de fenêtre recevant la lumière directe du soleil pendant au moins plusieurs heures chaque jour. Une fois les dernières gelées passées, vous pouvez transplanter dans de plus grands pots en extérieur.
Si vous êtes déjà en plein dans la saison de culture, pas d’inquiétude ! Vous pouvez trouver des plantes en pot dans la plupart des pépinières. Autrement, demandez à un ami une bouture et propagez-la dans un verre d’eau jusqu’à voir émerger les racines.
La menthe peut-elle pousser avec d’autres plantes ?
Absolument ! Vous pouvez faire pousser de la menthe avec un éventail d’autres plantes, comme le cannabis, l’origan, la lavande, l’aneth, le basilic, le romarin et la sauge. Toutes ces espèces possèdent différentes molécules qui composent leur huile essentielle. C’est la raison pour laquelle elles attirent et repoussent des espèces d’insectes différentes. Avoir une polyculture de plantes différentes poussant ensemble offre la meilleure défense contre les nuisibles et c’est le meilleur moyen d’attirer les prédateurs et pollinisateurs bénéfiques.


Quels sont les risques à cultiver de la menthe dans votre jardin de cannabis ?
Alors que la menthe offre de sérieux avantages pour votre jardin de cannabis, vous devez prendre des précautions pour vous assurer que la culture de cette plante ne vous échappe pas. Comme il s’agit d’une plante vivace robuste, de nombreuses espèces de menthe reviennent saison après saison en survivant sous forme de rhizomes sous la terre. Alors que cela garantit un afflux constant de feuilles de menthe fraîches, ces cultures souterraines peuvent rapidement envahir les parterres. Si vous les laissez faire, les plants de menthe étoufferont rapidement les autres espèces dans le jardin.
Pour cette raison, vous devriez toujours cultiver la menthe dans des pots ou autres récipients et non dans une plate-bande ou directement en terre.
Le cannabis et la menthe : une vie en harmonie
Vous savez tout. Les espèces de menthe sont des alliés de poids dans un jardin de cannabis, tant qu’elles sont cultivées en gardant à l’esprit leur tendance invasive. Leurs huiles essentielles, regorgeant de terpènes comme le menthol, aident à repousser les pucerons et autres nuisibles. Elles produisent également des terpènes quand elles sont attaquées, alertant ainsi les plantes voisines d’une menace potentielle. Bien sûr, avoir accès à des feuilles de menthe fraîches tous les jours en fait une plante indispensable à chaque jardinier !



Be as smart as an ancient Egyptian and grow multi-purpose peppermint in your garden.
Buy Peppermint Royal Guardians
Be as smart as an ancient Egyptian and grow multi-purpose peppermint in your garden.
- https://www.ncbi.nlm.nih.gov/pmc/articles/PMC8199371/
- https://www.sciencedaily.com/releases/2021/12/211201085147.htm
- https://pubmed.ncbi.nlm.nih.gov/18579110/
- https://onlinelibrary.wiley.com/doi/10.1111/tpj.14077
- https://onlinelibrary.wiley.com/doi/10.1002/fft2.53
- https://doi.org/10.1111/tpj.14077
- https://doi.org/10.3390%2Fmolecules26041118
- https://doi.org/10.1002/ps.6681
- https://doi.org/10.29312/remexca.v10i3.678
- https://doi.org/10.1111/tpj.15453
